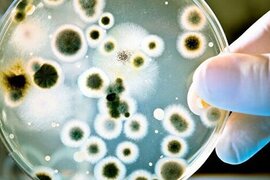
.

Sağlamlıq xəbərləri
Bu ölkədə karantin müddəti yenidən azaldılır
Gürcüstanda koronavirusun yayılmasına görə tətbiq olunan karantin müddətinin beynəlxalq təcrübəyə əsasən yenidən azaldılacağı gözlənilir. "Report"-a istinadən məlumat verir ki, ölkənin Baş naziri İrakli Qaribaşvili məsələnin müzakirəsini Səhiyyə Nazirliyi və Xəstəliklərə Nəzarət və İctima
8 fevral 2022
Bu ölkədə artıq 4-cü doza vaksin vurulur
Polşada koronavirusa qarşı 4-cü doza peyvənd prosesinə başlanılıb. Peyvəndin 4-cü dozası üçün 3-cü dozadan sonra 5 ay keçməlidir. xarici mətbuata istinadən xəbər verir ki, müvafiq olaraq, 4-cü doza xərçəng müalicəsi nəticəsində immun çatışmazlığı olan insanlara, orqan transplantasiyasından sonra ilki
8 fevral 2022
"Pfizer" uşaqlara necə təsir edir?
ABŞ-ın "Pfizer" və Almaniyanın "BioNTech" şirkətlərinin koronavirusa qarşı vaksininin 2 dozası uşaqlara gözləniləndən az təsir edir. "Report"-a istinadən xəbər verir ki, "Pfizer"in məlumatına görə, vaksinin 2-4 yaşlı uşaqlara təsiri 57 faiz, 6 aydan 2 yaşa qədə
7 fevral 2022
Bu ölkədə iki ildən sonra qadağalar ləğv olnur
"2 ildir ki, dünyanı cənginə alan koronavirus həyatımızda çox şeyi dəyişdi. Virusla həyatımıza bir çox qadağalar girərkən, peyvənd və daha az ölümcül "Omicron" sayəsində ilk dəfə tunelin sonunda işığı görürük. Koronavirusa qarşı ən sərt tədbirlər görən ölkələrdən biri olan Avstraliyanı
7 fevral 2022
Peyvənd olunanların sayı açıqlanıb
Azərbaycanda bu gün 32 276 nəfər vaksinasiya olunub. " xəbər verir ki, bu barədə Nazirlər Kabineti yanında Operativ Qərargah məlumat yayıb. Gün ərzində birinci mərhələ üzrə vaksinasiya olunanların sayı 2 457, ikinci mərhələ üzrə vaksinasiya olunanların sayı 1 632 nəfər təşkil edib. Ölkədə buste
6 fevral 2022
Azərbaycanda daha 7 474 nəfər koronavirusa yoluxub, 25 nəfər ölüb.
Azərbaycanda bu gün koronavirus infeksiyasına 7 474 yeni yoluxma faktı qeydə alınıb, 4 840 nəfər müalicə olunaraq sağalıb və evə buraxılıb. " xəbər verir ki, bu barədə Nazirlər Kabineti yanında Operativ Qərargah məlumat yayıb. Son sutkada 25 nəfər COVID-19-dan dünyasını dəyişib
6 fevral 2022
Azərbaycanda pandemiya sona çatır?Həkim açıqladı
Son günlər ölkədə virusa yoluxma halları sürətlə artmaqdadır və bu günə qədər olan say yoluxmanın ən pik həddidir. Mövcud vəziyyətlə bağlı həkim-infeksionist Nəzrin Mustafayevanın -a müsahibəsini təqdim edirik:. - Ölkədə virusa yoluxma halları 7 mini ötüb. Səhiyyə ocaqlarının bu xəstələri yerləşdirmə
6 fevral 2022
Dünyada koronavirusa yoluxma hallarının sayı 400 milyona çatır
Dünyada qeydə alınan koronavirusa yoluxma hallarının sayı 393 milyon 261 min 365-ə çatıb. "Report" xəbər verir ki, bu barədə ABŞ-ın Cons Hopkins Universiteti məlumat yayıb. Qeyd edilir ki, dünyada COVID-19-un yayılması başlayandan indiyədək 5 milyon 734 min 449 nəfər dünyasını dəyişib. Koronavirus
6 fevral 2022
Gürcüstanda daha 19 098 nəfərdə COVID-19 aşkarlanıb, 38 nəfər ölüb
Gürcüstanda ötən sutkada koronavirusa 19 098 yeni yoluxma faktı qeydə alınıb, 38 nəfər vəfat edib. "Report"un yerli bürosu xəbər verir ki, bu barədə ölkənin Xəstəliklərə Nəzarət və İctimai Saqlamlıq Milli Mərkəzindən bildirilib. Bununla da indiyədək qonşu ölkədə COVID-19-a yoluxanların say
6 fevral 2022
Ərdoğanla xanımının səhhəti ilə bağlı - Açıqlama
Koronavirusun "omicron" ştamına yoluxan Türkiyə Prezidenti Rəcəb Tayyib Ərdoğan və həyat yoldaşı Əminə Ərdoğanın səhhəti yaxşıdır. " xəbər verir ki, bu barədə Türkiyənin səhiyyə naziri Fahrettin Koca məlumat paylaşıb. Nazir qeyd edib ki, Prezidentin səhhəti işinə mane olmayacaq qədər yaxşıdı
5 fevral 2022
Peyvənd olunanların sayı bu dəfə neçədir?
Azərbaycanda bu gün 36 448 nəfər vaksinasiya olunub. " xəbər verir ki, bu barədə Nazirlər Kabineti yanında Operativ Qərargah məlumat yayıb. Gün ərzində birinci mərhələ üzrə vaksinasiya olunanların sayı 3 098, ikinci mərhələ üzrə vaksinasiya olunanların sayı 2 025 nəfər təşkil edib. Ölkədə buste
5 fevral 2022
Azərbaycanda koronavirusa yoluxma sayı açıqlandı
Azərbaycanda bu gün koronavirus infeksiyasına 7 704 yeni yoluxma faktı qeydə alınıb, 4 109 nəfər müalicə olunaraq sağalıb və evə buraxılıb. " xəbər verir ki, bu barədə Nazirlər Kabineti yanında Operativ Qərargah məlumat yayıb. Son sutkada 23 nəfər COVID-19-dan dünyasını dəyişib
5 fevral 2022
Ərdoğan və həyat yoldaşı koronavirusa yoluxdu
Türkiyə Prezidenti Rəcəb Tayyib Ərdoğan koronavirusa yoluxub. " xəbər verir ki, bunu dövlət başçısı tviterdə yazıb. R.T.Ərdoğanda koronavirusun "Omikron" ştamı aşkarlanıb. "Bu gün yüngül əlamətlərindən dolayı həyat yoldaşımla birlikdə verdiyimiz COVID-19 testimizin nəticəsi müsbə
5 fevral 2022
İranda ötən sutka ərzində 64 nəfər koronavirusdan ölüb
İranda ötən sutka ərzində 64 nəfər koronavirusdan (COVID-19) ölüb. APA-nın Tehran bürosunun məlumatına görə, bunu İranın Səhiyyə, Müalicə və Tibbi Təhsil Nazirliyi elan edib. Türkiyədə son sutkada koronavirusdan 157 nəfər ölüb. Türkiyə və ABŞ arasında "F-35"lə bağlı danışıqlar yanvarın son
5 fevral 2022
Bu ölkədə maska taxmaq məcburiyyəti aradan qadırılır
Bütün dünyada "COVİD-19" pandemiyasının artdığı bir vaxtda İspaniya hökuməti açıq havada maska taxmaq məcburiyyətinin qaldırılacağını açıqladı. xarici mətbuata istinadən məlumat verir ki, İspaniyanın səhiyyə naziri Karolin Dariyas ölkədə maska qadağasının gələn həftədən qaldırılacağını
5 fevral 2022
Bu vitamin 11 NÖV XƏRÇƏNG riskini azaldır
Elm adamları vitamin qəbulu ilə xərçəngin müxtəlif növləri arasında əlaqəni tədqiq edən 3562 elmi məqalənin nəticələri təhlil ediblər. "Frontiers in Nutrition" jurnalına istinadən xəbər verir ki, müəyyən bir vitamin qəbul etməklə, hətta 11 növ xərçəng riskini azaltmaq və ömrü uzatmaq mümkündür
4 fevral 2022
Bu dərmandan istifadə etməklə qara ciyərinizi zədələyə bilərsiniz - XƏBƏRDARLIQ
Koronavirus xəstəliyinin ilkin simptomları olan bəzi vətəndaşlar həkimə müraciət etmədən ev şəraitində müalicə olunurlar. xəbər verir ki, öskürək, halsızlıq və boğaz və əzələ ağrıları zamanı həkim resepti olmadan "Paracetamol" və "Strepsis" kimi ağrıkəsicilərdən istifadə edirlər
4 fevral 2022
Təzyiqi salmaq üçün dərman əvəzinə bu şirəni için
Yüksək arterial təzyiq insanın ümumi sağlamlığı üçün ən ziyanlı amillərdən biridir. Bu səbəbdən arterial təzyiqi normada saxlamaq həyati vacib olan məsələdir. Bəzən bunun üçün qidalanmada müəyyən dəyişikliklər etmək, pəhrizə bəzi təzyiqi normallaşdıran qida və ya içkiləri daxil etmək kifayətdir. Bel
3 fevral 2022
İnfarkt riskini proqnozlaşdıran süni intellekt sistemi hazırlanıb
Belçika alimləri gözün torlu qişasının skan edilməsi sayəsində infarkt riskini proqnozlaşdıran süni intellekt sistemi hazırlayıblar. -ın -a istinadən verdiyi məlumata görə, Leuven Universitetindən bir qrup tədqiqatçının apardığı araşdırmada ürək-damar xəstəliklərində gözün tor qişasındakı kapilyarları
3 fevral 2022
Yeni Zelandiya mərhələli şəkildə sərhədlərini açır
Avstraliyadan peyvənd olunmuş Yeni Zelandiyalılar fevralın 27-dən evlərinə qayıda, digər ölkələrin peyvənd olunmuş vətəndaşları isə martın 13-dən Yeni Zelandiyaya girə biləcəklər. Trend-ə istinadən verdiyi məlumata görə, bu barədə ölkənin baş naziri Casinda Ardern deyib. Bütün ölkəyə gələnlər 10 gü
3 fevral 2022
Hansı şəraitdə "Omicron"a yoluxmaq riski artır?
Yaponiyalı alimlər "Omicron" ştammından qorunmaq üçün maskaların effektivliyini təsdiqləyiblər. -ın xarici KİV-ə istinadən verdiyi məlumata görə, xəstə şəxs maska taxsa və onunla bir metr və ya daha çox məsafə saxlanılsa, yeni "Omicron" variantından yoluxma riski çox aşağı olur
3 fevral 2022
Burada tualetdən daha çox mikrob olur - GÖZLƏNİLMƏZ FAKT
İngiltərənin Aston Universitetinin tədqiqatçıları müxtəlif nəqliyyat vasitələrinin içərisində olan bakteriyaları araşdırıblar. xarici KİV-ə istinadən məlumat verir ki, komanda xüsusən avtomobil baqajlarında yüksək miqdarda zərərli bakteriyaların olduğunu müəyyən edib. Palçıqlı çəkmələrlə avtomobilə minməkdə
3 fevral 2022
Omicrona görə koronavirusa yoluxanların sayı 61 faiz artıb
İranın paytaxtı Tehranda koronavirusa yoluxanların sayı ötən həftə ilə müqayisədə 61 faiz artıb. -ın APA- Tehran bürosunun məlumatına görə, bunu Tehran şəhərinin meri Möhsün Mənsuri bu gün keçirdiyi mətbuat konfransında deyib. O bildirib ki, koronavirusun Omicron variantı ölkədə, o cümlədən Tehrand
2 fevral 2022
Ürək-damar xəstəlikləri olanlar vaksin vurdurmalıdır?
"Pandemiyanin nəzarət altına alınmasının tək yolu vaksinasiyadır". APA-ya istinadən xəbər verir ki, bunu Səhiyyə Nazirliyinin mütəxəssis-eksperti, kardioloq İlqar Tahiroğlu "Ürək-damar xəstəlikləri və COVID-19" mövzusunda çıxışında deyib. O bildirib ki, ürək-damar xəstəlikləri ola
2 fevral 2022
"Omicron" xəstələri bu qidaları YEMƏMƏLİDİR
İnfeksiyaya qarşı mübarizədə qidalanma mühüm rol oynayır. Ona görə də düzgün qidaların qəbulu orqanizmin xəstəliklə daha yaxşı mübarizə aparmasına kömək edəcək. "m24"-ə istinadən məlumat verir ki, rusiyalı diyetoloq, tibb elmləri doktoru Marqarita Korolyova "Omicron" ştammına yoluxanlar
2 fevral 2022
"Omikron"nun təhlükəli fəsadı
Koronavirusun "Omikron" ştammı səs tellərinə ciddi ziyan vura bilər. Bu barədə rusiyalı otorinolarinqoloq və tibb elmləri namizədi Vladimir Zaitsev bildirib. O, vurğulayıb ki, sözügedən ştamm səsin xırıltısı və hətta tam itkisi ilə təhdid edir:. "Əgər udlağın arxa divarı və damaq badamcıqlar
1 fevral 2022
Pfizer 4 yaşa qədər uşaqlara COVİD-19 peyvəndi üçün icazə alacaq
Pfizer və BioNTech şirkətləri 6 aydan 4 yaşa qədər uşaqlarda iki doza koronavirus peyvəndinin istifadəsi üçün ABŞ Qida və Dərman İdarəsinə müraciət edəcək. -ın xarici KİV-ə itinadən verdiyi məlumata görə, Pfizer idarə heyətinin üzvü və keçmiş Qida və Dərman Administrasiyasının komissarı Skot Qotlie
1 fevral 2022
"Yoluxma rekord həddə çata bilər"- Qapanmalarla bağlı infeksionistdən AÇIQLAMA
Son vaxtlar əhali arasında boğaz ağrısı, hərarət, halsızlıq çox müşahidə olunur. "Omicron" ştammına yoluxma fonunda bu kimi halların adi mövsümi qrip, yoxsa yeni ştamm olduğunu necə müəyyən etmək olar? Bildiyimiz kimi, 'Omicron" ştammı koronavirusun digər versiyalarına nisbətdə dah
31 yanvar 2022
Azərbaycan postpandemiya dövründə BMT-nin yüksək səviyyəli panelinin yaradılmasını təklif edib
"Biz COVID-19-dan sonra ümumi bərpa üzrə BMT-nin yüksək səviyyəli panelinin yaradılmasını təklif edirik. O, postpandemiya dövründə qlobal tədbirlər barədə tövsiyələr hazırlayacaq". xəbər verir ki, bu fikirləri Prezident İlham Əliyev "Rossiya 24" telekanalında yayımlanan "Hakimiyyə
30 yanvar 2022
Prezident: "Bizim təşkil etdiyimiz, həyata keçirdiyimiz işi Ümumdünya Səhiyyə Təşkilatı da qiymətləndirib"
"Bizim təşkil etdiyimiz, həyata keçirdiyimiz işi Ümumdünya Səhiyyə Təşkilatı da qiymətləndirib". xəbər verir ki, bunu Prezidenti İlham Əliyev yanvarın 30-da "Rossiya 24" telekanalında TASS informasiya agentliyinin baş direktorunun birinci müavini Mixail Qusmanın Azərbaycanın dövlə
30 yanvar 2022
Zərgər gətirilən bir çanta qızılı qəbul etmədi: "Bu günaha girə bilmərəm"
Prezident bu şəxsləri təltif etdi (SİYAHI)
Səhər yeməyini ötürsək nə baş verər?
Meyxanaçı Kərim vəfat etdi
Pul boşa gedir: Bu beş smartfonu alanlar peşman olur
"Hazırda "bomj" kimi bir həyat yaşayıram..."
Tanınmış kosmetoloq Natavan Əmirova paylaşımı ilə özünü biabır edib
Çində günəş elektrik stansiyası səhranı "oyandırdı" - Alimlər
Nazirdən iki təyinat
Aysundan Rəqsanəyə İRAD: "Səhv deyirsən" - VİDEO
"Qoç ət"in dönərindən 20 sm tük çıxıb? - "Əməkdaşlarımız saçı qısa olan kişilərdir"
Kərim harda dəfn olunacaq? (AÇIQLAMA)
Baş Prokurorluq Kamran Əsədov və "şərikləri" ilə bağlı - Açıqlama yaydı
Həyat yoldaşına qaraciyərini bağışladı: "Canım idi, ciyərim oldu"
Ekspert "ən sağlam" çay haqqında mifi dağıtdı
